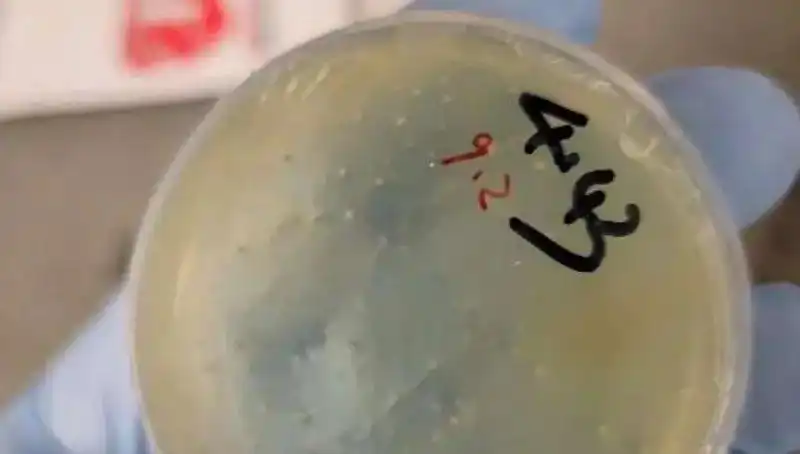

Gizli Biyolojik Madde Skandalı: Çinli Bilim Adamı Havalimanında Yakalandı
Çinli bilim insanı, yasa dışı biyolojik maddelerle birlikte havalimanında yakalandı; olay uluslararası gerilim yarattı.
Son günlerde dünya genelinde yankı uyandıran bir skandal, Çinli bir bilim insanının havalimanında yakalanmasıyla gündeme geldi. Yasa dışı biyolojik maddelerle donatılan ve önemli verilerle taşınan bu kişi, uluslararası güvenlik güçlerinin dikkatini çekti ve olay büyük bir tartışma başlattı. Bu durum, biyolojik güvenlik ve bilimsel etik konularında ciddi sorgulamalara yol açarken, aynı zamanda hükümetler arası gerginlikleri de tetikledi.
Yakalanmanın Ayrıntıları
Olay, geçtiğimiz günlerde bir uluslararası havalimanında gerçekleşti. Yetkililer, rutin güvenlik kontrolleri sırasında Çinli bilim insanını durdurdu ve çantasında yasadışı biyolojik maddeler buldu. Bu maddelerin ne amaçla kullanıldığı henüz açıklanmasa da, bazı uzmanlar bu durumun siber savaşların ve biyolojik tehditlerin arttığı bir çağda son derece kaygı verici olduğunu belirtiyor. Bilim insanının, laboratuvar ortamında ürettiği bazı tehlikeli organizmalarla birlikte seyahat ettiği öne sürülüyor. Olayın ardından, Çin hükümeti, bilim insanının hukuki haklarını korumak amacıyla derhal bir açıklama yaptı. Ayrıca, ilgili üniversite ve araştırma kurumlarından da bilgi talep edildi.
Uluslararası Tepkiler ve Tartışmalar
Bu olay, sadece bir bireyin yakalanması değil, aynı zamanda biyolojik güvenlik alanındaki kuralların ve etik normların nasıl ihlal edildiğine dair önemli sorular ortaya çıkardı. Birçok ülke, olayın ardından biyolojik maddelerin taşınmasıyla ilgili yasalarını gözden geçirme kararı aldı. Konuyla ilgili yorum yapan uluslararası güvenlik uzmanları, bu tür biyolojik maddelerin yanlış ellere geçmesinin potansiyel tehlikelerine dikkat çekiyor. Bilim insanlarının, bilimsel araştırmalar sırasında etik kurallara uyum sağlaması gerektiği vurgulanıyor. Bu olay, bilim dünyasında güvenin nasıl sarsıldığını ve etik kaygıların ön planda tutulması gerektiğini bir kez daha gündeme getirdi.
Öte yandan, sosyal medya platformlarında da olaya ilişkin yoğun tartışmalar yürütülüyor. Kullanıcılar, bu olayın nasıl sonuçlanacağını ve Çin hükümetinin konuya yaklaşımını sorgularken, uzmanlar olayı "biyolojik casusluk" olarak nitelendiriyor. Biyolojik güvenlik alanındaki bu tür kazaların, ülkeler arası ilişkileri nasıl etkileyebileceği ve bilim insanlarının uluslararası işbirlikleri içinde ne gibi sorunlarla karşılaşabileceği gibi önemli konular öne çıkıyor.
Olayın gelişimiyle birlikte, uluslararası hükümetler arasında yapılan görüşmelerin, bilimsel etkileşimlerin ve güvenlik ortaklıklarının nasıl şekilleneceği merak konusu olmaya devam ediyor. Kısa vadede, bu tür olayların önlenmesi için daha sıkı denetimlerin ve standartların getirilip getirilmeyeceği, bilim topluluğunda en çok tartışılan konulardan biri oldu.
Kısacası, Çinli bilim insanının havalimanında yakalanması, hem bilim dünyası hem de uluslararası ilişkiler açısından ciddi meseleleri gündeme taşımış durumda. Bu olay, biyolojik güvenlik, etik ve uluslararası işbirliği konularında derin bir tartışmanın başlangıcını işaret ediyor. Gelecek günlerde bu konudaki gelişmeler merakla takip edilecektir.